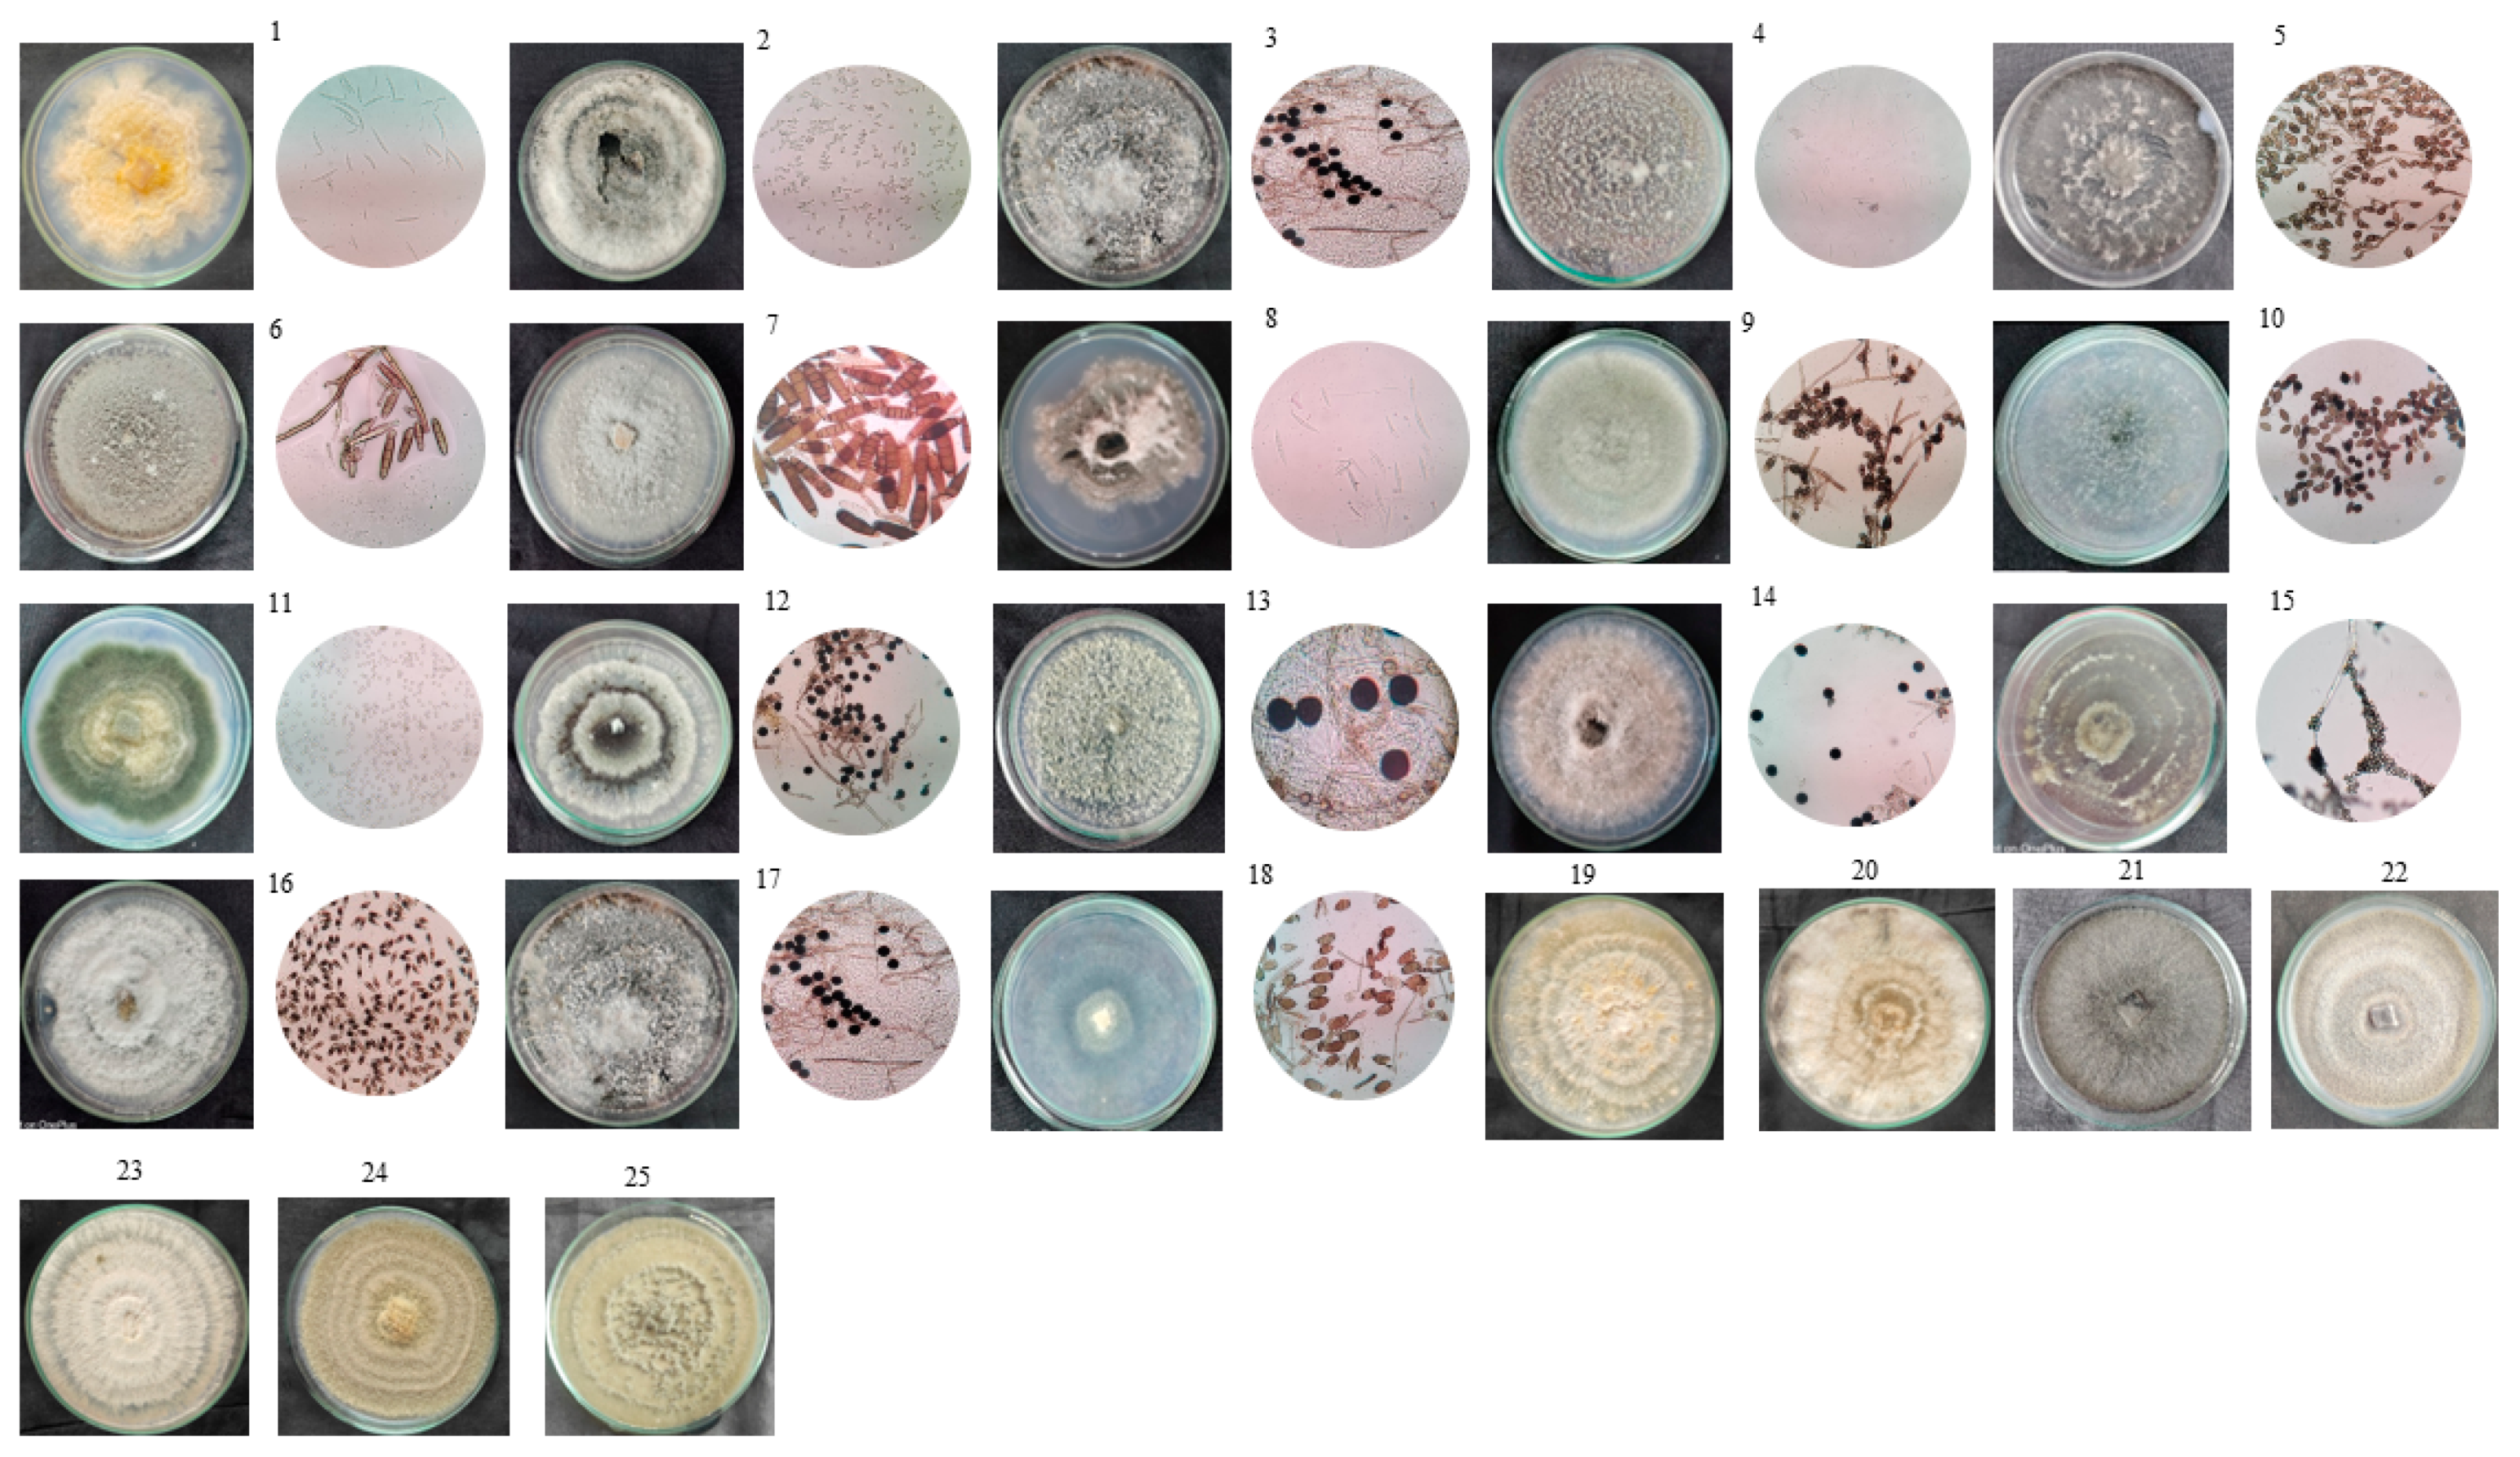
Microbiolres 15 00053 g002

Endophytic Fungal Diversity in Hardwickia binata: Bridging the Gap between Traditional and Modern Techniques
Abstract
1. Introduction
2. Materials and Methods
2.1. Materials Used
2.2. Description of the Site, Selection of Plants, and Soil Analysis
2.3. Collection of Plant Samples
2.4. Culture-Dependent Approach
2.4.1. Endophytic Fungi Isolation and Morphological Characterization
2.4.2. Assembling Sequences and Phylogenetic Tree Construction
2.4.3. ITS2 Secondary Structure Prediction
2.5. Culture-Independent Approach
DNA Extraction and Metagenomic Analysis
2.6. Data Analysis in the Pipeline
3. Results
3.1. Soil Analysis
3.2. Culture-Dependent
Cultured Endophytic Fungus: Diversity and Community Structure
3.3. Prediction of ITS 2 Secondary Structure
3.4. Culture-Independent
Examination of Endophytic Fungal Community Structures Using a Culture-Independent Approach
3.5. Examining Operational Taxonomic Units
3.6. Rarefaction Analysis and Richness Estimates
3.7. Culture-Dependent versus Culture-Independent
4. Discussion
5. Conclusions
Supplementary Materials
Author Contributions
Funding
Institutional Review Board Statement
Informed Consent Statement
Data Availability Statement
Acknowledgments
Conflicts of Interest
References
- Hyde, K.D.; Soytong, K. The fungal endophyte dilemma. Fungal Divers. 2018, 33, e173. [Google Scholar]
- Jin, H.; Yang, X.; Lu, D.; Li, C.; Yan, Z.; Li, X.; Zeng, L.; Qin, B. Phylogenic diversity and tissue specificity of fungal endophytes associated with the pharmaceutical plant, Stellera chamaejasme L. revealed by a cultivation-independent approach. Antonie Van Leeuwenhoek 2015, 108, 835–850. [Google Scholar] [CrossRef]
- Fadiji, A.E.; Ayangbenro, A.S.; Babalola, O.O. Metagenomic profiling of the community structure, diversity, and nutrient pathways of bacterial endophytes in maize plant. Antonie Van Leeuwenhoek 2020, 113, 1559–1571. [Google Scholar] [CrossRef]
- Wu, B.; Hussain, M.; Zhang, W.; Stadler, M.; Liu, X.; Xiang, M. Current insights into fungal species diversity and perspective on naming the environmental DNA sequences of fungi. Mycology 2019, 10, 127–140. [Google Scholar] [CrossRef]
- Verma, V.C.; Singh, S.K.; Kharwar, R.N. Histological Investigation of Fungal Endophytes in Healthy Tissues of Azadirachta indica A. Juss. Agric. Nat. Resour. 2012, 46, 229–237. [Google Scholar]
- Arnold, A.E.; Henk, D.A.; Eells, R.L.; Lutzoni, F.; Vilgalys, R. Diversity and phylogenetic affinities of foliar fungal endophytes in loblolly pine inferred by culturing and environmental PCR. Mycologia 2007, 99, 185–206. [Google Scholar] [CrossRef]
- Suryanarayanan, T.S.; Murali, T.S.; Thirunavukkarasu, N.; Rajulu, G.; Venkatesan, G.; Sukumar, R. Endophytic fungal communities in woody perennials of three tropical forest types of the Western Ghats, southern India. Biodivers. Conserv. 2011, 20, 913–928. [Google Scholar] [CrossRef]
- Shingade, S.P.; Kakde, R.B. A Review on “Anjan” Hardwickia binata Roxb: Its Phytochemical Studies, Traditional uses and Pharmacological activities. Pharmacogn. Rev. 2021, 15, 65. [Google Scholar] [CrossRef]
- Høyer, A.K.; Hodkinson, T.R. Hidden fungi: Combining culture-dependent and-independent DNA barcoding reveals inter-plant variation in species richness of endophytic root fungi in Elymus repens. J. Fungi 2021, 7, 466. [Google Scholar] [CrossRef]
- Hawksworth, D.L.; Lücking, R. Fungal diversity revisited: 2.2 to 3.8 million species. Microbiol. Spectr. 2017, 5, 1–17. [Google Scholar] [CrossRef]
- Miguel, P.S.B.; de Oliveira, M.N.V.; Delvaux, J.C.; de Jesus, G.L.; Borges, A.C.; Tótola, M.R.; Costa, M.D. Diversity and distribution of the endophytic bacterial community at different stages of Eucalyptus growth. Antonie Van Leeuwenhoek 2016, 109, 755–771. [Google Scholar] [CrossRef]
- Mashiane, R.A.; Ezeokoli, O.T.; Adeleke, R.A.; Bezuidenhout, C.C. Metagenomic analyses of bacterial endophytes associated with the phyllosphere of a Bt maize cultivar and its isogenic parental line from South Africa. World J. Microbiol. Biotechnol. 2017, 33, 1–12. [Google Scholar] [CrossRef]
- Bálint, M.; Bahram, M.; Eren, A.M.; Faust, K.; Fuhrman, J.A.; Lindahl, B.; Tedersoo, L. Millions of reads, thousands of taxa: Microbial community structure and associations analyzed via marker genes. FEMS Microbiol. Rev. 2016, 40, 686–700. [Google Scholar] [CrossRef]
- Peršoh, D. Plant-associated fungal communities in the light of meta’omics. Fungal Divers. 2015, 75, 1–25. [Google Scholar] [CrossRef]
- Ghosh, S.; Das, A.P. Metagenomic insights into the microbial diversity in manganese-contaminated mine tailings and their role in biogeochemical cycling of manganese. Sci. Rep. 2018, 8, 8257. [Google Scholar] [CrossRef]
- Alves, L.D.F.; Westmann, C.A.; Lovate, G.L.; de Siqueira, G.M.V.; Borelli, T.C.; Guazzaroni, M.E. Metagenomic approaches for understanding new concepts in microbial science. Int. J. Genom. 2018, 2018, 2312987. [Google Scholar] [CrossRef]
- Shokralla, S.; Spall, J.L.; Gibson, J.F.; Hajibabaei, M. Next-generation sequencing technologies for environmental DNA research. Mol. Ecol. 2012, 21, 1794–1805. [Google Scholar] [CrossRef]
- Al-Bulushi, I.M.; Bani-Uraba, M.S.; Guizani, N.S.; Al-Khusaibi, M.K.; Al-Sadi, A.M. Illumina MiSeq sequencing analysis of fungal diversity in stored dates. BMC Microbiol. 2017, 17, 72. [Google Scholar] [CrossRef]
- Mani, I.; Thangavel, M.; Surendrababu, A.; Sneha, M.; Rajagopal, R.; Alfarhan, A.; Pandi, M. Unveiling the Bioprospecting Efficacy and Textile Dyeing of a Novel Endophytic Mycobial Red Pigment. Indian J. Microbiol. 2024, 1–17. [Google Scholar] [CrossRef]
- Kjer, J.; Debbab, A.; Aly, A.H.; Proksch, P. Methods for isolation of marine-derived endophytic fungi and their bioactive secondary products. Nat. Protoc. 2010, 5, 479–490. [Google Scholar] [CrossRef] [PubMed]
- Cenis, J.L. Rapid extraction of fungal DNA for PCR amplification. Nucleic Acids Res. 1992, 20, 2380. [Google Scholar] [CrossRef] [PubMed]
- GokulRaj, K.; Sundaresan, N.; Ganeshan, E.J.; Rajapriya, P.; Muthumary, J.; Sridhar, J.; Pandi, M. Phylogenetic reconstruction of endophytic fungal isolates using internal transcribed spacer 2 (ITS2) region. Bioinformation 2014, 10, 320. [Google Scholar] [CrossRef] [PubMed][Green Version]
- Keller, A.; Schleicher, T.; Schultz, J.; Müller, T.; Dandekar, T.; Wolf, M. 5.8 S-28S rRNA interaction and HMM-based ITS2 annotation. Gene 2009, 430, 50–57. [Google Scholar] [CrossRef]
- Del Carmen Flores-Vallejo, R.; Folch-Mallol, J.L.; Sharma, A.; Cardoso-Taketa, A.; Alvarez-Berber, L.; Villarreal, M.L. ITS2 ribotyping, in vitro anti-inflammatory screening, and metabolic profiling of fungal endophytes from the Mexican species Crescentia alata Kunth. S. Afr. J. Bot. 2020, 134, 213–224. [Google Scholar] [CrossRef]
- Bokulich, N.A.; Subramanian, S.; Faith, J.J.; Gevers, D.; Gordon, J.I.; Knight, R.; Caporaso, J.G. Quality-filtering vastly improves diversity estimates from Illumina amplicon sequencing. Nat. Methods 2013, 10, 57–59. [Google Scholar] [CrossRef]
- Kõljalg, U.; Nilsson, R.H.; Abarenkov, K.; Tedersoo, L.; Taylor, A.F.; Bahram, M.; Larsson, K.H. Towards a unified paradigm for sequence-based identification of fungi. Mol. Ecol. 2013, 22, 5271–5277. [Google Scholar] [CrossRef]
- Nair, D.N.; Padmavathy, S.J.T.S.W.J. Impact of endophytic microorganisms on plants, environment and humans. Sci. World J. 2014, 2014, 250693. [Google Scholar] [CrossRef]
- Dos Reis, J.B.A.; Lorenzi, A.S.; do Vale, H.M.M. Methods used for the study of endophytic fungi: A review on methodologies and challenges, and associated tips. Arch. Microbiol. 2022, 204, 675. [Google Scholar] [CrossRef]
- Verma, V.; Srivastava, A.; Garg, S.K.; Singh, V.P.; Arora, P.K. Incorporating omics-based tools into endophytic fungal research. Biotechnol. Notes 2023, 5, 1–7. [Google Scholar] [CrossRef]
- Hirakue, A.; Sugiyama, S. Relationship between foliar endophytes and apple cultivar disease resistance in an organic orchard. Biol. Control 2018, 127, 139–144. [Google Scholar] [CrossRef]
- Adeleke, B.S.; Babalola, O.O. Pharmacological potential of fungal endophytes associated with medicinal plants: A review. J. Fungi 2021, 7, 147. [Google Scholar] [CrossRef]
- Ahrendt, S.R.; Quandt, C.A.; Ciobanu, D.; Clum, A.; Salamov, A.; Andreopoulos, B.; Grigoriev, I.V. Leveraging single-cell genomics to expand the fungal tree of life. Nat. Microbiol. 2018, 3, 1417–1428. [Google Scholar] [CrossRef]
- Wijayawardene, N.N.; Bahram, M.; Sánchez-Castro, I.; Dai, D.Q.; Ariyawansa, K.G.; Jayalal, U.; Tedersoo, L. Current insight into culture-dependent and culture-independent methods in discovering Ascomycetous Taxa. J. Fungi 2021, 7, 703. [Google Scholar] [CrossRef]
- Yao, Y.Q.; Lan, F.; Qiao, Y.M.; Wei, J.G.; Huang, R.S.; Li, L.B. Endophytic fungi harbored in the root of Sophora tonkinensis Gapnep: Diversity and biocontrol potential against phytopathogens. MicrobiologyOpen 2017, 6, e00437. [Google Scholar] [CrossRef]
- Gong, A.; Zhou, T.; Xiao, C.; Jiang, W.; Zhou, Y.; Zhang, J.; Zhang, C. Association between dipsacus saponin VI level and diversity of endophytic fungi in roots of Dipsacus asperoides. World J. Microbiol. Biotechnol. 2019, 35, 1–14. [Google Scholar] [CrossRef]
- Rojas, E.C.; Sapkota, R.; Jensen, B.; Jørgensen, H.J.; Henriksson, T.; Jørgensen, L.N.; Collinge, D.B. Fusarium head blight modifies fungal endophytic communities during infection of wheat spikes. Microb. Ecol. 2020, 79, 397–408. [Google Scholar] [CrossRef]
- Ruiz Gómez, F.J.; Navarro-Cerrillo, R.M.; Pérez-de-Luque, A.; Oβwald, W.; Vannini, A.; Morales-Rodríguez, C. Assessment of functional and structural changes of soil fungal and oomycete communities in holm oak declined dehesas through metabarcoding analysis. Sci. Rep. 2019, 9, 5315. [Google Scholar] [CrossRef]
- Forbes, J.D.; Knox, N.C.; Ronholm, J.; Pagotto, F. Metagenomics: The next culture-independent game changer. Front. Microbiol. 2017, 8, 261928. [Google Scholar] [CrossRef]
- Parmar, S.; Li, Q.; Wu, Y.; Li, X.; Yan, J.; Sharma, V.K.; Li, H. Endophytic fungal community of Dysphania ambrosioides from two heavy metal-contaminated sites: Evaluated by culture-dependent and culture-independent approaches. Microb. Biotechnol. 2018, 11, 1170–1183. [Google Scholar] [CrossRef]
- Khalil, A.M.A.; Hassan, S.E.D.; Alsharif, S.M.; Eid, A.M.; Ewais, E.E.D.; Azab, E.; Fouda, A. Isolation and characterization of fungal endophytes isolated from medicinal plant Ephedra pachyclada as plant growth-promoting. Biomolecules 2021, 11, 140. [Google Scholar] [CrossRef]
- Amirita, A.; Sindhu, P.; Swetha, J.; Vasanthi, N.S.; Kannan, K.P. Enumeration of endophytic fungi from medicinal plants and screening of extracellular enzymes. World J. Sci. Technol. 2012, 2, 13–19. [Google Scholar]
- Rampersad, S.N. ITS1, 5.8 S and ITS2 secondary structure modelling for intra-specific differentiation among species of the Colletotrichum gloeosporioides sensu lato species complex. SpringerPlus 2014, 3, 684. [Google Scholar] [CrossRef]
- Kapoor, N.; Gambhir, L.; Saxena, S. Secondary structure prediction of ITS rRNA region and molecular phylogeny: An integrated approach for the precise speciation of Muscodor species. Ann. Microbiol. 2018, 68, 763–772. [Google Scholar] [CrossRef]
- Prahl, R.E.; Khan, S.; Deo, R.C. The role of internal transcribed spacer 2 secondary structures in classifying mycoparasitic Ampelomyces. PLoS ONE 2021, 16, e0253772. [Google Scholar] [CrossRef]
- Koetschan, C.; Kittelmann, S.; Lu, J.; Al-Halbouni, D.; Jarvis, G.N.; Müller, T.; Janssen, P.H. Internal transcribed spacer 1 secondary structure analysis reveals a common core throughout the anaerobic fungi (Neocallimastigomycota). PLoS ONE 2014, 9, e91928. [Google Scholar] [CrossRef]
- Ahvenniemi, P.; Wolf, M.; Lehtonen, M.J.; Wilson, P.; German-Kinnari, M.; Valkonen, J.P. Evolutionary diversification indicated by compensatory base changes in ITS2 secondary structures in a complex fungal species, Rhizoctonia solani. J. Mol. Evol. 2009, 69, 150–163. [Google Scholar] [CrossRef]
- Sundaresan, N.; Sahu, A.K.; Jagan, E.G.; Pandi, M. Evaluation of ITS2 molecular morphometrics effectiveness in species delimitation of Ascomycota–A pilot study. Fungal Biol. 2019, 123, 517–527. [Google Scholar] [CrossRef]
- Pang, K.L.; Guo, S.Y.; Chen, I.A.; Burgaud, G.; Luo, Z.H.; Dahms, H.U.; Cha, H.J. Insights into fungal diversity of a shallow-water hydrothermal vent field at Kueishan Island, Taiwan by culture-based and metabarcoding analyses. PLoS ONE 2019, 14, e0226616. [Google Scholar] [CrossRef]
- Chi, W.C.; Chen, W.; He, C.C.; Guo, S.Y.; Cha, H.J.; Tsang, L.M.; Pang, K.L. A highly diverse fungal community associated with leaves of the mangrove plant Acanthus ilicifolius var. xiamenensis revealed by isolation and metabarcoding analyses. PeerJ 2019, 7, e7293. [Google Scholar] [CrossRef]
- Donovan, P.D.; Gonzalez, G.; Higgins, D.G.; Butler, G.; Ito, K. Identification of fungi in shotgun metagenomics datasets. PLoS ONE 2018, 13, e0192898. [Google Scholar] [CrossRef]
- Sugiyama, A.; Vivanco, J.M.; Jayanty, S.S.; Manter, D.K. Pyrosequencing assessment of soil microbial communities in organic and conventional potato farms. Plant Dis. 2010, 94, 1329–1335. [Google Scholar] [CrossRef]
- Dissanayake, A.J.; Purahong, W.; Wubet, T.; Hyde, K.D.; Zhang, W.; Xu, H.; Yan, J. Direct comparison of culture-dependent and culture-independent molecular approaches reveal the diversity of fungal endophytic communities in stems of grapevine (Vitis vinifera). Fungal Divers. 2018, 90, 85–107. [Google Scholar] [CrossRef]
- Nischitha, R.; Shivanna, M.B. Comparative Metagenomic Analyses of Endophytic Fungi Assemblages in Shoot and Root Regions of Heteropogon contortus. Proc. Natl. Acad. Sci. USA 2024, 94, 161–167. [Google Scholar] [CrossRef]
- Kaul, S.; Sharma, T.; Dhar, M.K. “Omics” tools for better understanding the plant–endophyte interactions. Front. Plant Sci. 2016, 7, 183603. [Google Scholar] [CrossRef]
- Zhang, Q.; Xue, X.Z.; Miao, S.M.; Cui, J.L.; Qin, X.M. Differential relationship of fungal endophytic communities and metabolic profiling in the stems and roots of Ephedra sinica based on metagenomics and metabolomics. Symbiosis 2020, 81, 115–125. [Google Scholar] [CrossRef]
- Macías-Rubalcava, M.L.; Sánchez-Fernández, R.E.; Roque-Flores, G.; Lappe-Oliveras, P.; Medina-Romero, Y.M. Volatile organic compounds from Hypoxylon anthochroum endophytic strains as postharvest mycofumigation alternative for cherry tomatoes. Food Microbiol. 2018, 76, 363–373. [Google Scholar] [CrossRef]
- Sumbula, V.; Kurian, P.S.; Girija, D.; Cherian, K.A. Impact of foliar application of fungicides on tomato leaf fungal community structure revealed by metagenomic analysis. Folia Microbiol. 2022, 67, 103–108. [Google Scholar] [CrossRef]
- Jayawardena, R.S.; Purahong, W.; Zhang, W. Biodiversity of fungi on Vitis vinifera L. revealed by traditional and high-resolution culture-independent approaches. Fungal Divers. 2018, 90, 1–84. [Google Scholar] [CrossRef]
- Pei, C.; Mi, C.; Sun, L.; Liu, W.; Li, O.; Hu, X. Diversity of endophytic bacteria of Dendrobium officinale based on culture-dependent and culture-independent methods. Biotechnol. Biotechnol. Equip. 2017, 31, 112–119. [Google Scholar] [CrossRef]

| Soil Nutrients | Hardwickia binata |
|---|---|
| NPK | 2:1:1 |
| Electrical conductivity | 0.65 dS/m |
| pH | 7.4 |
| Fe | 2.34 |
| Mn | 1.74 |
| Zn | 1.35 |
| Cu | 1.59 |
| B | 0.35 |
| Phylum | Class | Order | Family | Genus | Species |
|---|---|---|---|---|---|
| Ascomycota | Ascomycetes | Sphaeriales | Sordariaceae | Sordaria | Sordaria fimicola |
| Dothideomycetes | Pleosporales | Didymellaceae | Didymella | Didymella macrostoma | |
| Dothideomycetes | Botryosphaeriales | Botryosphaeriaceae | Sphaeropsis | Sphaeropsis visci | |
| Dothideomycetes | Pelosporales | Pleosporaceae | Curvularia | Curvularia geniculate Curvularia lunata (2) Curvularia americana | |
| Dothideomycetes | Patellariales | Patellariaceae | Rhytidhysteron | Rhytidhysteron rufulum (2) | |
| Dothideomycetes | Pelosporales | Pleosporaceae | Pithomyces | Pseudopithomyces karoo | |
| Dothideomycetes | Botryosphaeriales | Botryosphaeriaceae | Phyllosticta | Phyllosticta paracapitelams | |
| Eurotiomycetes | Eurotiales | Trichocomaceae | Aspergillus | Aspergillus sydowii Aspergillus eburneocremeus | |
| Eurotiomycetes | Eurotiales | Trichocomaceae | Talaromyces | Talaromyces verruculosus | |
| Sordariomycetes | Hypocreales | Nectriaceae | Fusarium | Fusarium hainanense Fusarium incarnatum | |
| Sordariomycetes | Diaporthales | Valsaceae | Phomopsis | Phoma macrostoma | |
| Sordariomycetes | Diaporthales | Diaporthaceae | Diaporthe | Diaporthe biconispora | |
| Sordariomycetes | Trichosphaeriales | Trichosphaeriaceae | Nigrospora | Nigrospora lacticolonia Nigrospora sphaerica Nigrospora oryzae | |
| Sordariomycetes | Xylariales | Xylariaceae | Xylaria | Xylaria psidii | |
| Sardariomycetes | Xylariales | sporacadaceae | Pestalotiopsis | Pestalotiopsis telopeae | |
| Sordariomycetes | Xylariales | Hypoxylaceae | Daldinia | Daldinia eschscholtzii | |
| Basidomycota | Agaricomycetes | Agaricales | Psathyrellaceae | Coprinellus | Coprinellus radians |
| Culture-Dependent Approach | Culture-Independent Approach | ||||||
|---|---|---|---|---|---|---|---|
| Fungal Isolates | Shannon Diversity Index | Simpson Diversity Index | Total Reads | OTU’s | Shannon Diversity Index | Simpson Diversity Index | |
| H. binata | 25 | 2.75444 | 0.367 | 69,570 | 269 | 3.8558 | 0.8445 |
Disclaimer/Publisher’s Note: The statements, opinions and data contained in all publications are solely those of the individual author(s) and contributor(s) and not of MDPI and/or the editor(s). MDPI and/or the editor(s) disclaim responsibility for any injury to people or property resulting from any ideas, methods, instructions or products referred to in the content. |
© 2024 by the authors. Licensee MDPI, Basel, Switzerland. This article is an open access article distributed under the terms and conditions of the Creative Commons Attribution (CC BY) license (https://creativecommons.org/licenses/by/4.0/).
Share and Cite
Joe Xavier Sneha, M.; Thangavel, M.; Mani, I.; Rajapriya, P.; Ponnuraj, N.; Pandi, M. Endophytic Fungal Diversity in Hardwickia binata: Bridging the Gap between Traditional and Modern Techniques. Microbiol. Res. 2024, 15, 823-840. https://doi.org/10.3390/microbiolres15020053
Joe Xavier Sneha M, Thangavel M, Mani I, Rajapriya P, Ponnuraj N, Pandi M. Endophytic Fungal Diversity in Hardwickia binata: Bridging the Gap between Traditional and Modern Techniques. Microbiology Research. 2024; 15(2):823-840. https://doi.org/10.3390/microbiolres15020053
Chicago/Turabian StyleJoe Xavier Sneha, Michael, Myithili Thangavel, Israel Mani, Pandy Rajapriya, Nagendraprabhu Ponnuraj, and Mohan Pandi. 2024. "Endophytic Fungal Diversity in Hardwickia binata: Bridging the Gap between Traditional and Modern Techniques" Microbiology Research 15, no. 2: 823-840. https://doi.org/10.3390/microbiolres15020053
APA StyleJoe Xavier Sneha, M., Thangavel, M., Mani, I., Rajapriya, P., Ponnuraj, N., & Pandi, M. (2024). Endophytic Fungal Diversity in Hardwickia binata: Bridging the Gap between Traditional and Modern Techniques. Microbiology Research, 15(2), 823-840. https://doi.org/10.3390/microbiolres15020053

